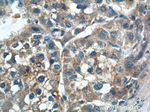
SGSH Antibody in Immunohistochemistry (Paraffin) (IHC (P))

Search
Proteintech
SGSH Polyclonal Antibody
{{$productOrderCtrl.translations['antibody.pdp.commerceCard.promotion.promotions']}}
{{$productOrderCtrl.translations['antibody.pdp.commerceCard.promotion.viewpromo']}}
{{$productOrderCtrl.translations['antibody.pdp.commerceCard.promotion.promocode']}}: {{promo.promoCode}} {{promo.promoTitle}} {{promo.promoDescription}}. {{$productOrderCtrl.translations['antibody.pdp.commerceCard.promotion.learnmore']}}
产品信息
14184-1-AP
种属反应
宿主/亚型
分类
类型
抗原
偶联物
形式
浓度
规格
纯化类型
保存液
内含物
保存条件
运输条件
产品详细信息
Immunogen sequence: ITRIKLLVR KFLQTQDDRP FFLYVAFHDP HRCGHSQPQY GTFCEKFGNG ESGMGRIPDW TPQAYDPLDV LVPYFVPNTP AARADLAAQY TTVGRMDQGV GLVLQELRDA GVLNDTLVIF TSDNGIPFPS GRTNLYWPGT AEPLLVSSPE HPKRWGQVSE AYVSLLDLTP TILDWFSIPY PSYAIFGSKT IHLTGRSLLP ALEAEPLWAT VFGSQSHHEV TMSYPMRSVQ HRHFRLVHNL NFKMPFPIDQ DFYVSPTFQD LLNRTTAGQP TGWYKDLRHY YYRARWELYD RSRDPHETQN LATDPRFAQL LEMLRDQLAK WQWETHDPWV CAPDGVLEEK LSPQCQPLHN EL (152-502 aa encoded by BC047318)
靶标信息
SGSH is one of several enzymes involved in the lysosomal degradation of heparan sulfate. Mutations in this gene are associated with Sanfilippo syndrome A, one type of the lysosomal storage disease mucopolysaccaridosis III, which results from impaired degradation of heparan sulfate. Transcripts of varying sizes have been reported but their biological validity has not been determined.
仅用于科研。不用于诊断过程。未经明确授权不得转售。
篇参考文献 (0)
生物信息学
蛋白别名: heparan sulfate sulfatase; mucopolysaccharidosis type IIIA; N-sulphoglucosamine sulphohydrolase; Sulfoglucosamine sulfamidase; Sulphamidase; unnamed protein product
基因别名: HSS; MPS3A; SFMD; SGSH
UniProt ID: (Human) P51688
Entrez Gene ID: (Human) 6448